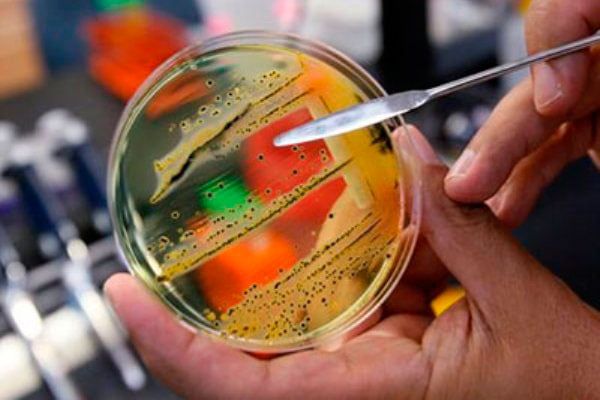

Ситуация находится под контролем Главного управления Госсанэпидслужбы в Запорожской области
Главное управление Госсанэпидслужбы в Запорожской области сообщает, что за период с 06.09.2015 по 11.09.2015 года после празднования свадьбы в городе Бердянске в ресторане «Черчилль» за помощью с проявлениями острых кишечных инфекций обратилось 17 больных, среди которых было 3 детей. Их состояние – средней тяжести. У 10 больных выявленно сальмонеллу блегдам.
Специалистами Главного управления Госсанэпидслужбы в Запорожской области и Бердянского межрайонного управления Госсанэпидслужбы в Запорожской области проведена проверка соблюдения санитарного законодательства в ресторане «Черчилль». Для проведения лабораторных исследований по установлению возбудителя отобраны смывы, пробы пищевых продуктов и питьевой воды.
Причиной заболевания послужила сальмонелла блегдам, которая была выделена как от заболевших, так и среди 2 человек, которые обслуживали свадьбы.
Представителями Госсанэпидслужбы при проверке ресторана «Черчилль», зафиксированы нарушения санитарного законодательства, а именно:
- нарушаются требования соблюдения последовательности и поточности технологического процесса;
- неупорядоченное прохождении обязательного профилактического медицинского осмотра у персонала, отсутствует маркировка на кухонной посуде;
- требуется обновление маркировки на обрабатывающем инвентаре (разделочных досках);
- производственные столы промаркированы частично;
- не представлены сопроводительные документы, подтверждающие качество на дезинфицирующее средство;
- на празднование свадьбы заказчиком принесенные пищевые продукты без сопроводительных документов, удостоверяющих их безопасность, и тому подобное.
С 70 отобранных смывов с внешней среды в 9 (12,8%) случаях выявлена условно-патогенная микрофлора.
Противоэпидемические мероприятия проводятся в полном объеме. Ситуация находится под контролем Главного управления Госсанэпидслужбы в Запорожской области